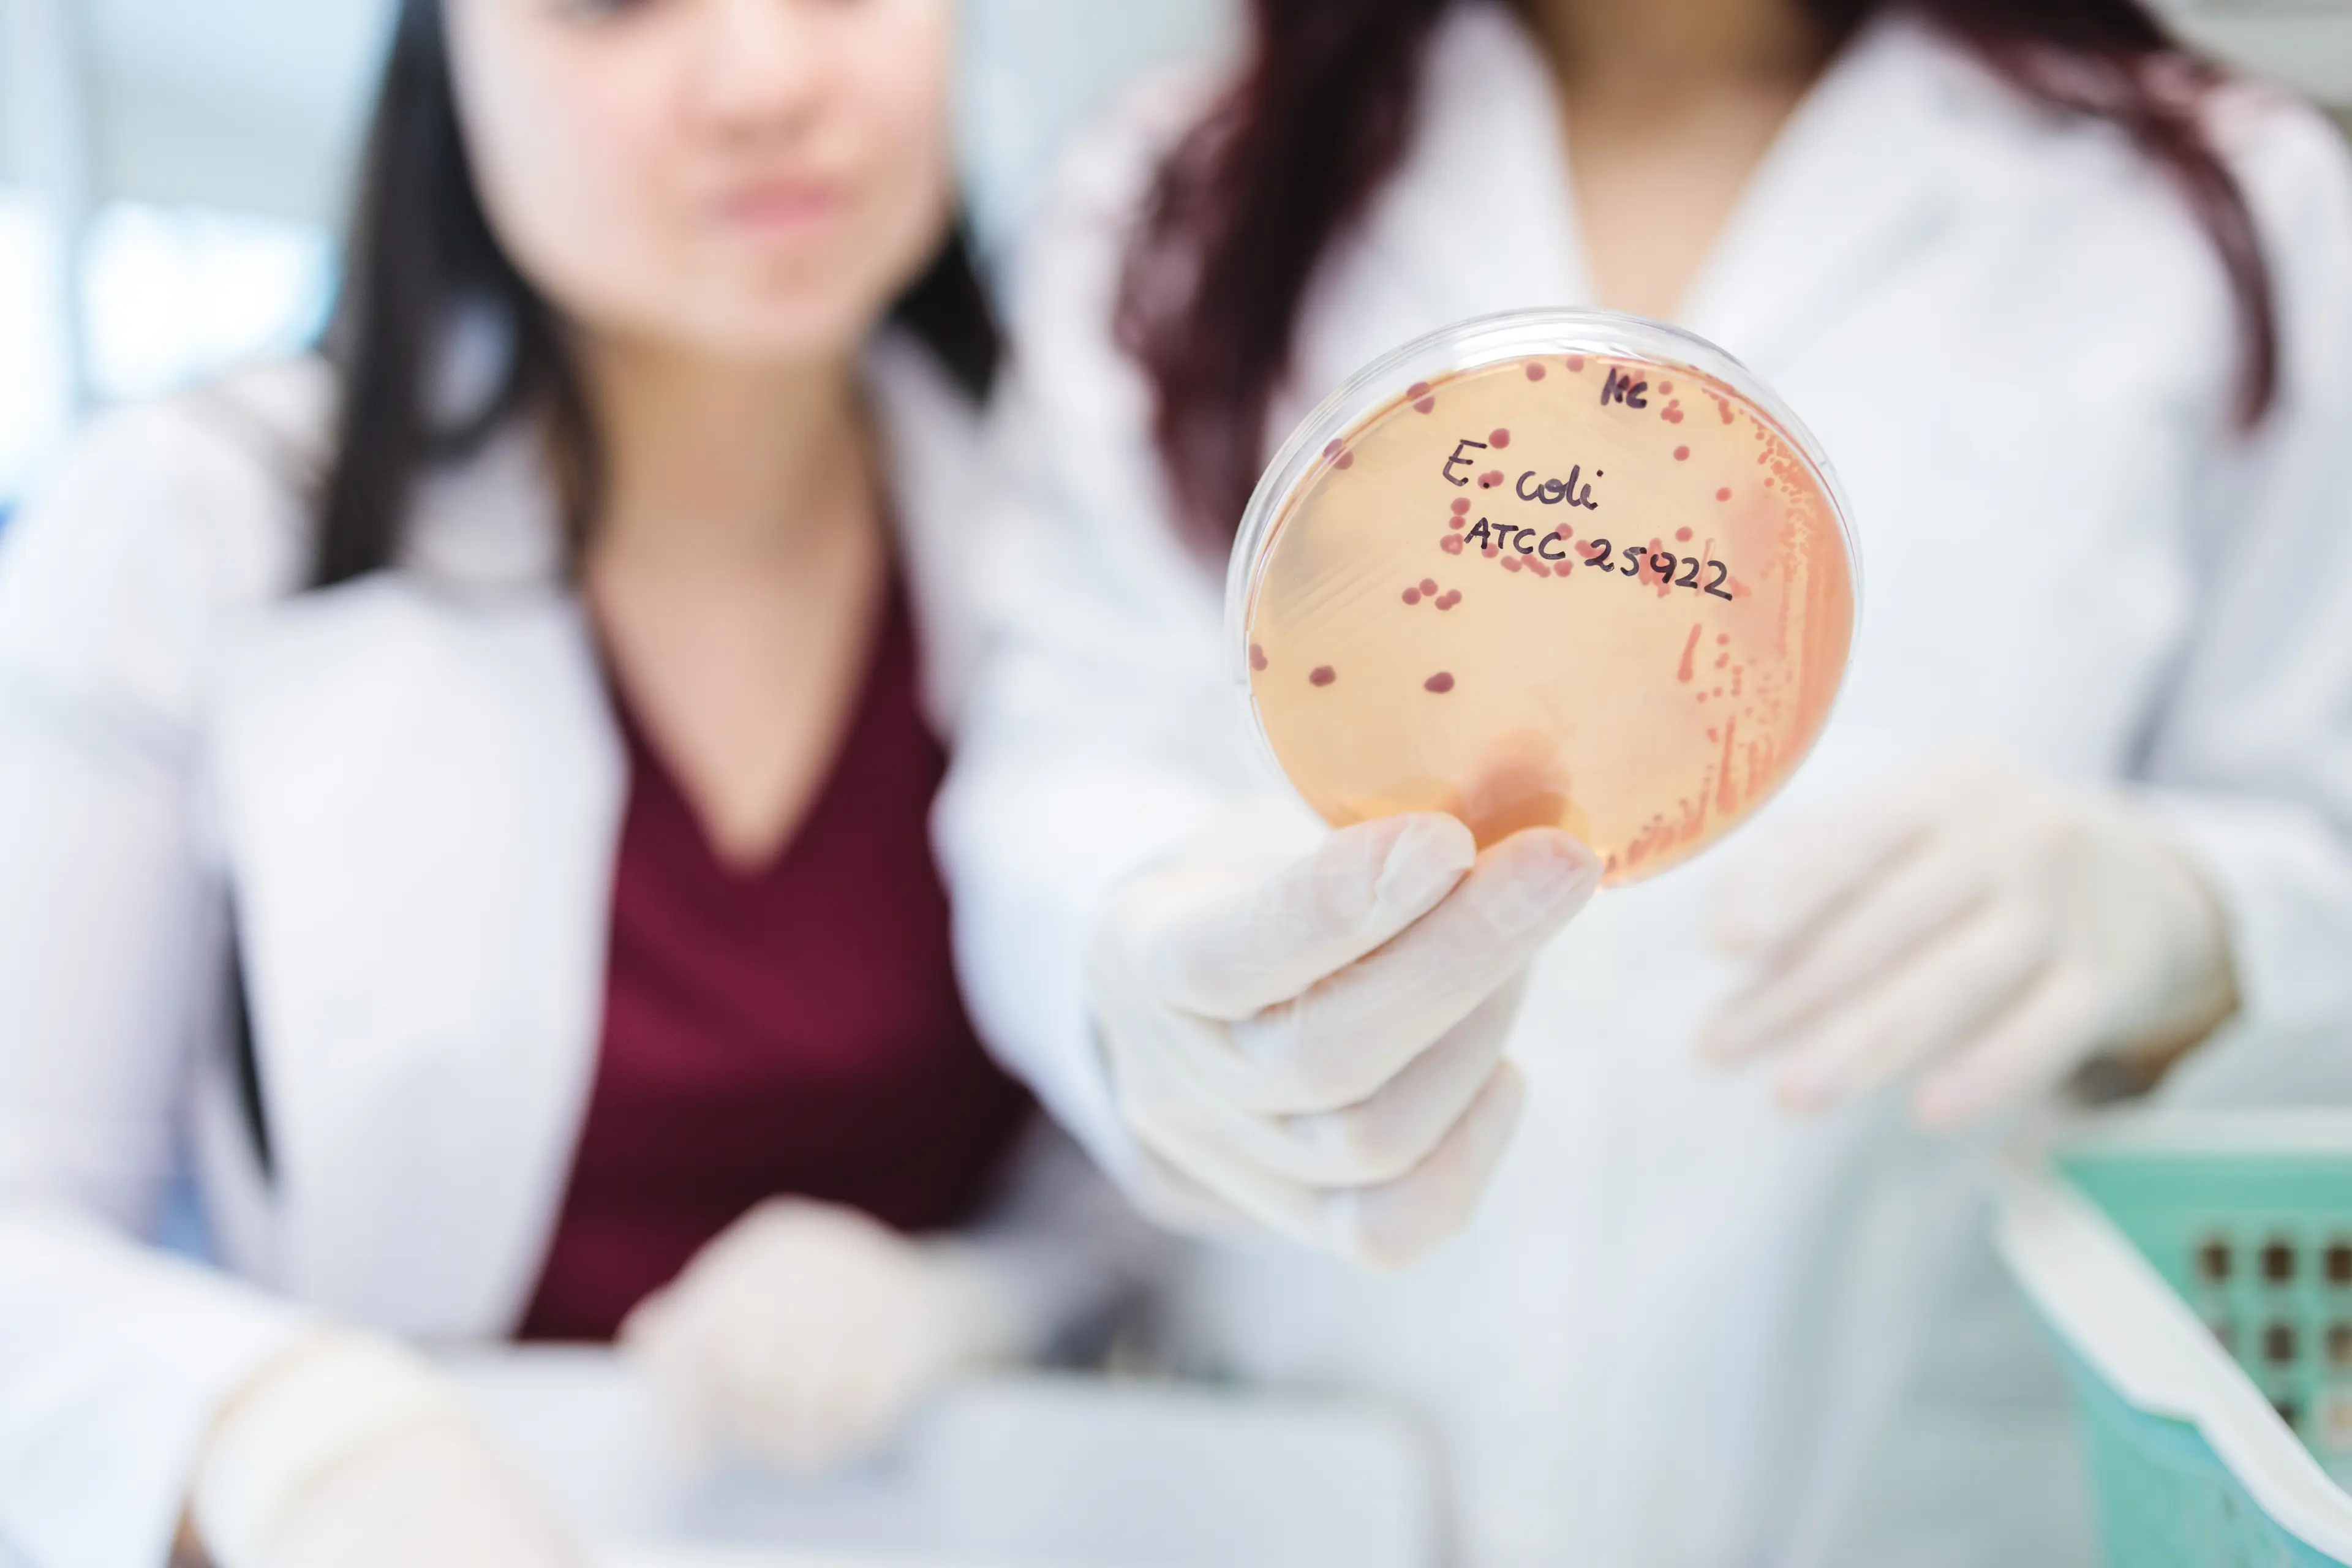
Marler has seen the devastating results of an E. coli infection (Getty Stock Image)

Topics: Food and Drink, Health, Life, True Life, Real Life
When attorney Bill Marler sits down to eat at a restaurant, he doesn't need to scan the menu to know there's one meal he absolutely won't be asking the chefs to whip up - and that's salad.
Such was the case recently, when the Seattle-based lawyer was invited down to culinary connoisseur Gordon Ramsay's upscale St. Louis eatery, Ramsay's Kitchen.
It wasn't that Marler didn't trust the Michelin-star British foodie; just that he knew all too well the potentially fatal effects of consuming salad gone bad.
That's actually why he was in St Louis - to attend a court hearing involving a handful of restaurant customers, all of whom had been allegedly struck down with sickness after chewing their way through romaine lettuce that had been tainted with E. coli.
Advert
This wouldn't be the first time that Marler would be called in to preside over such a case.
In fact, he's forged quite the career for himself over the last four decades, having sued countless big-dog eateries since the 90s for their part in spreading food-borne illnesses - some of which pose a threat to life.
He first found his calling after staff at the US fast-food chain Jack In The Box served undercooked hamburgers to its customers, infecting over 700 people and tragically killing four children.
The incident led to major nationwide food safety reforms, which Marler has made it his duty to stay on top of.
On top of not having eaten a hamburger in decades, he recently added another no-go to his dietary requirements - salad.
Not only will he avoid ordering it as a main at all costs, but when opting for a dish that comes with a side salad, he'll ask to swap the leafy greens for cooked vegetables.

"I tend to, because of my experience, take a more cautious approach to my food," Marler explained in conversation with the Washington Post, adding that the risks have changed over the years.
"I’ve seen too much. I’ve been in too many ICUs. I’ve been to too many funerals.
"I know too much."
Marler went on to add that, over the years, the dreaded E. coli O157:H7 pathogen - once closely linked to meat - has been more closely associated with infection through salad.
This disease, he says, can cause permanent kidney damage and death.
On top of this, he believes salad leaves have a propensity to spread the likes of Salmonella and Listeria.

Despite around 48 million cases of food-borne illnesses occurring in the US each year - striking as many as 1 in 6 Americans, with 3,000 per year proving fatal - Marler admits his own aversions go far beyond what federal health authorities recommend.
"I am at that age where food-borne pathogens could be really bad for you," he continued.
Asked how he informs restaurant staff and chefs of the specifics of his orders, Marler lastly admitted: "I explain what I do for a living. It’s an occupational hazard."